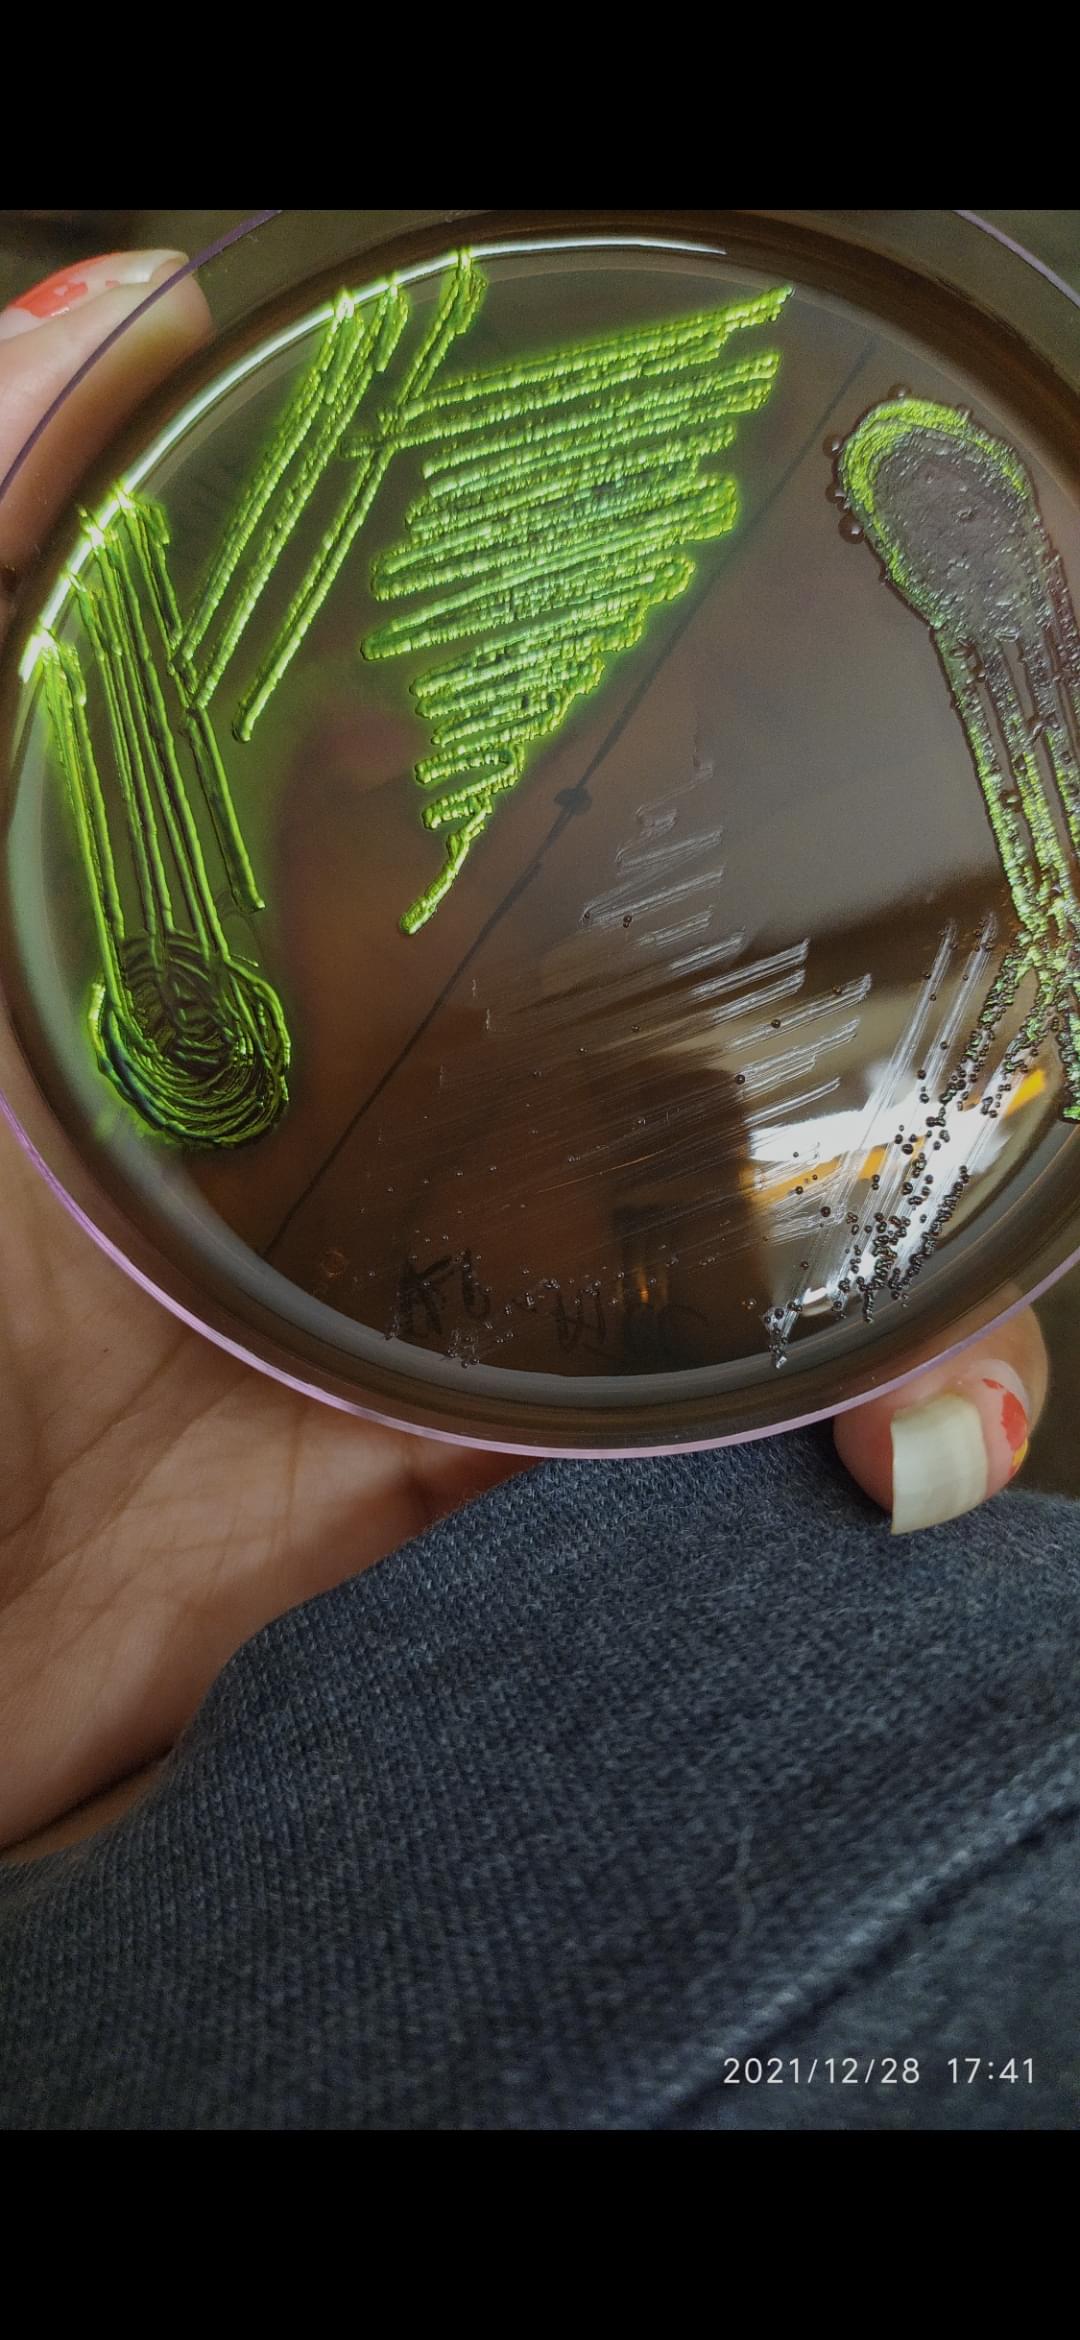

The institute features highly skilled faculty members who enhance student learning with effective doubt-clearing methods and innovative teaching approaches, focusing on fundamental concepts. Faculty are supportive and experienced in their subjects, fostering a strong educational environment. Final-year students from all departments can participate in campus placements, starting in the 10th semester. Around 10 companies, including notable recruiters like Wipro, visit the campus. The average salary package ranges from 2-3 lakh INR, with the highest reaching 10-12 lakh INR.
Placement opportunities are more abundant for BTech students, whereas biotechnology students often pursue further studies or careers in specialized fields. Internships, usually starting from the 6th semester, offer stipends of 10,000 to 15,000 INR and involve practical lab work in areas like cancer and genetics. Siksha O Anusandhan, a private university, provides affordable education with yearly fees for the Integrated MSc Biotechnology program between 85,000 to 100,000 INR, totaling approximately 500,000 INR over five years.
Hostel and mess charges are 78,000 INR annually. Scholarships, based on academic performance, require a minimum of 70%-80% in board exams and a CGPA of at least 8, though they are not universally available. Fees are payable quarterly, with an annual increase, and no part-time campus jobs are offered, but placement opportunities exist after course completion.

![Siksha 'O' Anusandhan University - [SOA]](https://image-static.collegedunia.com/public/college_data/images/logos/1619098174SOAPNG.png?h=71.7&w=71.7&mode=stretch)


.jpeg)
.jpeg)
.jpeg)







.jpeg?h=100&w=100&mode=stretch)
.jpeg?h=100&w=100&mode=stretch)
.jpeg?h=100&w=100&mode=stretch)

.png?h=78&w=78&mode=stretch)


![All India Institute of Medical Sciences - [AIIMS]](https://image-static.collegedunia.com/public/college_data/images/appImage/25753_AIIMS_NEW.jpg?h=111.44&w=263&mode=stretch)

![Institute of Medical Sciences and SUM Hospital - [IMS & SUM Hospital]](https://image-static.collegedunia.com/public/college_data/images/appImage/1509345040AppNew.jpg?h=111.44&w=263&mode=stretch)

![Kalinga Institute of Medical Sciences - [KIMS]](https://image-static.collegedunia.com/public/college_data/images/appImage/10619_KIMS_APP.jpg?h=111.44&w=263&mode=stretch)



![Hi-Tech Medical College and Hospital - [HMCH]](https://image-static.collegedunia.com/public/college_data/images/appImage/1755750770Screenshot20250821095933.png?h=111.44&w=263&mode=stretch)



![Institute of Health Sciences - [IHS]](https://image-static.collegedunia.com/public/college_data/images/appImage/1577775709IHS.jpg?h=111.44&w=263&mode=stretch)












![Institute of Dental Sciences - [IDS]](https://image-static.collegedunia.com/public/college_data/images/logos/1507123346Logo.jpg?h=72&w=72&mode=stretch)
.png?h=72&w=72&mode=stretch)




![Birla Global University - [BGU]](https://image-static.collegedunia.com/public/college_data/images/logos/1654260652bgulogo.png?h=72&w=72&mode=stretch)

![Odisha University of Technology and Research-[OUTR]](https://image-static.collegedunia.com/public/college_data/images/logos/1756463603Screenshot20250829155546.png?h=72&w=72&mode=stretch)


![Sri Sri University - [SSU]](https://image-static.collegedunia.com/public/college_data/images/logos/1506508878logo.jpg?h=72&w=72&mode=stretch)


![GITA Autonomous College - [GITA College]](https://image-static.collegedunia.com/public/college_data/images/logos/1623431523gitalog.png?h=72&w=72&mode=stretch)

![GIET University - [GIET]](https://image-static.collegedunia.com/public/college_data/images/logos/1620738578UniversityLogo1.png?h=72&w=72&mode=stretch)

![Centurion University of Technology and Management - [CUTM]](https://image-static.collegedunia.com/public/college_data/images/logos/16189222067038315326908908642635764348829995527831552n.jpg?h=72&w=72&mode=stretch)

![Kalinga Institute of Industrial Technology - [KIIT]](https://image-static.collegedunia.com/public/college_data/images/logos/1394450211Kalinga Institute of Industrial Technology.png?h=72&w=72&mode=stretch)
![Orissa University of Agriculture and Technology - [OUAT]](https://image-static.collegedunia.com/public/college_data/images/logos/1482315881logo.png?h=72&w=72&mode=stretch)

Comments